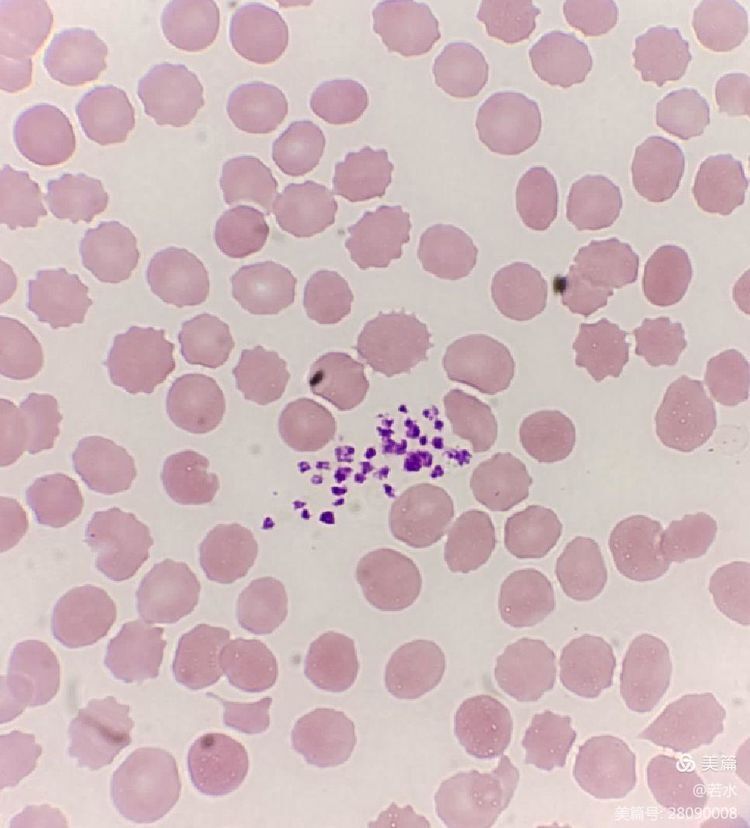
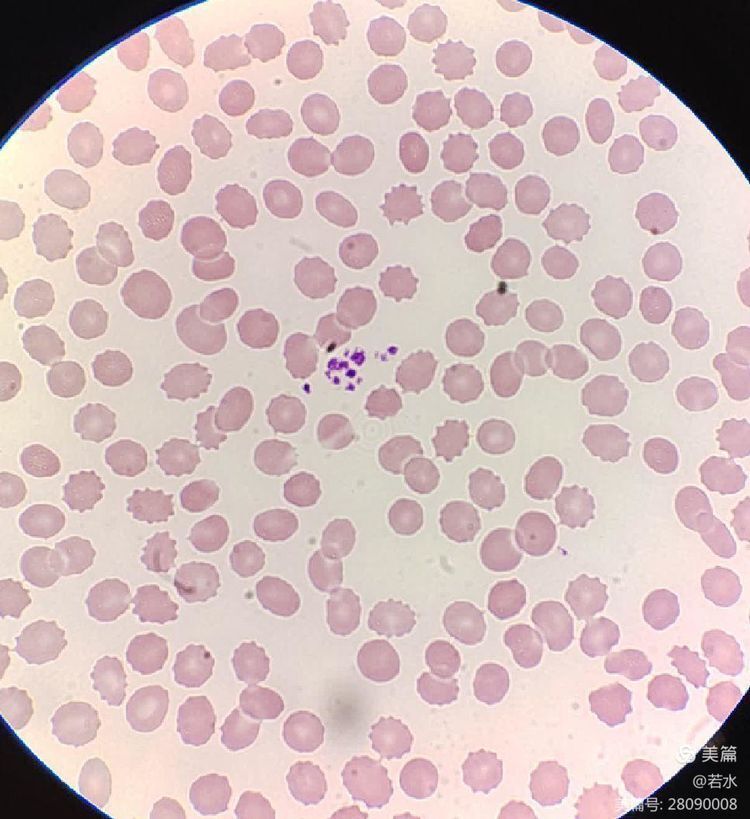
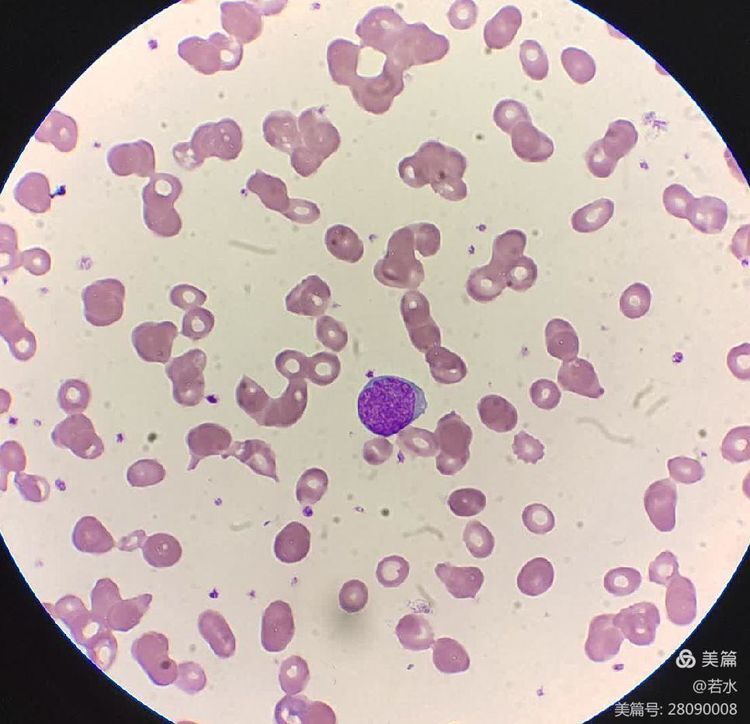

EDTA依赖性假性血小板减少(EDTA-PTCP)是由于使用EDTA抗凝全血后,血小板聚集导致使用血球仪检测血小板计数低于参考值下限的现象。
正如下面这例患者的情况所示。血液科门诊患者,男,40岁,曾在外院体检时发现血小板减少,遂来我院复查。复查结果血小板数是31.仍是减少!

仪器提示血小板聚集及巨血小板

血涂片镜检发现片尾部血小板成堆分布。

片中央也可见血小板有成簇分布。
片中央也可见血小板有成簇分布。
镜下所见的这种血小板成堆分布高度怀疑患者为EDTA依赖引起的血小板假性减少!为了进一步明确,我们第一时间联系患者进行了复查。
这次采血不用EDTA-K2抗凝剂管,而是用一个小试管加入机器本身的稀释液180uL,再加入末梢血20uL,混匀后上机检测,结果出来了,血小板数是214,不少了!

镜下所见血小板不再是成簇分布,而是一个一个散在且易见,说明血小板数处在正常范围。
借此病例,笔者与大家简单探讨一下关于EDTA依赖的血小板假性减少现象
EDTA-K2是血常规检测(俗称的紫头管)最常用的抗凝剂,因为血液在离体环境中会迅速凝固,因此血液离体后需要加入抗凝剂保持血液的流动状态,以检测血液当中的各种有形成分。大多数情况下,EDTA-K2既能够很好的保护血液细胞的形态,又能够较好的抑制血小板的聚集。而由于某些遗传因素或者药物等导致极少部分人群中EDTA对血液的抗凝作用失效,血小板就会变为聚集状态;目前我们所使用的血小板检测设备只能识别单个血小板,聚集的血小板由于体积增大不符合血小板的判读规则,往往就会导致血小板计数的假性降低。
EDTA依赖的血小板聚集在正常人群中0.1%-2%可见(与遗传因素有关),住院患者中0.4%-2%可见(可能与药物影响有关),也就是说即使你出现了EDTA依赖的血小板聚集,也并不意味着你是疾病状态,很可能只是一过性的现象,过段时间就会恢复,当然也可能会持续一段时间。
遇到EDTA依赖怎么办?
一般情况下,检验科工作人员遇到血小板降低的病人都会推片镜检,如果镜下观察到明显的血小板聚集,在排除抽血不畅等其他导致血小板降低的原因后,会重点排查EDTA-2K依赖的血小板聚集,这时您需要做的就是等待检验科或者医生通知并配合复查。对于非卧床或严格制动患者,优先选择让患者本人到门诊窗口直接扎手指进行复核:取末梢血立即稀释后上机检测,一般情况下都能够纠正血小板的假性减低;对于卧床或严格制动患者可以采用不同的抗凝剂采集血液标本进行复查即抽取患者蓝头管(枸橼酸钠抗凝)和绿头管(肝素抗凝)以及紫头管(EDTA-2K抗凝)三管血样进行检测。如若上述方法均不能纠正血小板检测结果,这时候就要考验检验科医务人员的基本功—计数板进行人工计数。总之,为了给您一个准确的结果,检验科医生会使出“十八般武艺”!
(供稿:孙伟娜 审核:杨海青)